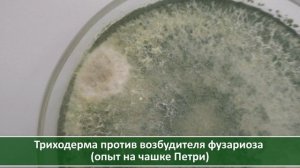
Что лучше: Максим или триходерма? Борьба с фузариозом озимого чеснока: эксперимент. Посадка осенью

3:33
3:33
2023-11-10 14:43

 4:02
4:02

 4:02
4:02
2023-07-08 12:33

 6:48
6:48

 6:48
6:48
2023-08-22 12:40
![Раствор уничтожает луковую муху наповал! Лук сразу становится красивым! Обработка от луковой мухи]() 2:22
2:22
 2:22
2:22
2021-06-10 12:30

 10:49
10:49

 10:49
10:49
2019-12-05 15:30

 5:17
5:17

 5:17
5:17
2025-02-03 22:20

 1:58:59
1:58:59

 1:58:59
1:58:59
2026-05-18 14:49

 51:51
51:51

 51:51
51:51
2026-06-15 18:00

 2:36:33
2:36:33

 2:36:33
2:36:33
2026-04-24 17:06

 1:11
1:11

 1:11
1:11
2026-06-13 00:51

 3:57:45
3:57:45

 3:57:45
3:57:45
2024-12-23 03:29

 1:23:60
1:23:60

 1:23:60
1:23:60
2026-06-15 14:25

 3:12:39
3:12:39

 3:12:39
3:12:39
2026-04-02 00:05

 1:12:36
1:12:36

 1:12:36
1:12:36
2026-06-08 16:49

 2:46:48
2:46:48

 2:46:48
2:46:48
2026-06-12 19:30

 1:35:25
1:35:25

 1:35:25
1:35:25
2026-04-26 20:10

 2:24:39
2:24:39

 2:24:39
2:24:39
2026-04-27 21:35

 1:41:07
1:41:07
![Ислам Мальсуйгенов и Зульфия Чотчаева - Путеводная (Премьера клипа 2026)]() 3:15
3:15
![Рейсан Магомедкеримов - Роза алая (Премьера клипа 2026)]() 3:52
3:52
![Артур Бесаев - Словно волк (Премьера клипа 2026)]() 3:32
3:32
![Фати Царикаева - Моё лето (Премьера клипа 2026)]() 2:22
2:22
![Arujan - Koz tiydime (Премьера клипа 2026)]() 3:24
3:24
![Сергей Одинцов - Моя недотрога (Премьера клипа 2026)]() 3:40
3:40
![Олег Семенов - Попутчица (Премьера клипа 2026)]() 3:00
3:00
![Рустам Нахушев - Загубила (Премьера клипа 2026)]() 3:31
3:31
![NAIMAN - Королева (Премьера клипа 2026)]() 3:02
3:02
![Ислам Итляшев - На руках (Премьера клипа 2026)]() 3:02
3:02
![Murat Gamidov - По ночам (Премьера клипа 2026)]() 2:53
2:53
![Руслан Добрый - Итальянка (Премьера клипа 2026)]() 2:14
2:14
![Артур Халатов - Покайфуем (Премьера клипа 2026)]() 3:40
3:40
![Enrasta - Адьёс (Премьера клипа 2026)]() 3:45
3:45
![Гоша Грачевский - Домой (Премьера клипа 2026)]() 2:50
2:50
![SEREBRO - Мало огня (Премьера клипа 2026)]() 1:52
1:52
![Фати Царикаева - Доброе утро (Премьера клипа 2026)]() 2:42
2:42
![Misty - Летай (Премьера клипа 2026)]() 2:30
2:30
![Ярослав Леонов - Майская роза (Премьера клипа 2026)]() 3:14
3:14
![Руслан Шанов, Amina T - Не верну я (Премьера клипа 2026)]() 2:31
2:31
![Чумовая пятница 2 | Freakier Friday (2025)]() 1:50:38
1:50:38
![На помощь! | Send Help (2026)]() 1:53:00
1:53:00
![Тайны моей сестры | My Sister's Bones (2026)]() 1:21:23
1:21:23
![Сначала дамы | Ladies First (2026)]() 1:33:24
1:33:24
![Восстание зловещих мертвецов | Evil Dead Rise (2023)]() 1:36:30
1:36:30
![Грозовой перевал | Wuthering Heights (2026)]() 2:16:14
2:16:14
![Опасные отношения | Over Your Dead Body (2026)]() 1:45:24
1:45:24
![Напоминание о нём | Reminders of Him (2026)]() 1:54:16
1:54:16
![Хищный рывок | Thrash (2026)]() 1:26:13
1:26:13
![Сестра | Siseuteo (2026)]() 1:26:45
1:26:45
![Острые козырьки: Бессмертный человек | Peaky Blinders: The Immortal Man (2026)]() 1:54:08
1:54:08
![Завещание Анны Ли | The Testament of Ann Lee (2025)]() 2:16:48
2:16:48
![Супер Марио: Галактическое кино | The Super Mario Galaxy Movie (2026)]() 1:38:18
1:38:18
![Нормал | Normal (2025)]() 1:31:23
1:31:23
![Джек Райан: Призрачная война | Jack Ryan: Ghost War (2026)]() 1:46:53
1:46:53
![Мортал Комбат 2 | Mortal Kombat II (2026)]() 1:55:45
1:55:45
![Мать Мария | Mother Mary (2026)]() 1:51:42
1:51:42
![Смертельно прекрасна | Pretty Lethal (2026)]() 1:30:46
1:30:46
![Крик 7 | Scream 7 (2026)]() 1:53:59
1:53:59
![Нескромные | Splitsville (2025)]() 1:44:43
1:44:43
![Сандра - сказочный детектив Сезон 1]() 13:52
13:52
![Забавные медвежата]() 13:00
13:00
![Псэмми. Пять детей и волшебство Сезон 1]() 12:17
12:17
![Команда Дино. Исследователи Сезон 1]() 13:10
13:10
![МиниФорс Сезон 1]() 13:12
13:12
![Сборники «Зебра в клеточку»]() 45:30
45:30
![Корги по имени Моко. Домашние животные]() 1:13
1:13
![Папа Супергерой Сезон 1]() 4:28
4:28
![Команда Дино. Исследователи Сезон 2]() 13:26
13:26
![Неодети]() 11:27
11:27
![Полли Покет Сезон 1]() 21:30
21:30
![МиниФорс]() 0:00
0:00
![Простоквашино. Финансовая грамотность]() 3:27
3:27
![Чуч-Мяуч]() 7:04
7:04
![Маугли и Акира. Новые приключения]() 11:11
11:11
![Енотки]() 7:08
7:08
![Пингвиненок Пороро]() 7:42
7:42
![Супер Зак]() 11:38
11:38
![Синдбад и семь галактик Сезон 1]() 10:23
10:23
![Сборники «Приключения Пети и Волка»]() 1:28:31
1:28:31
![Женщина лёгкого похудения - Уральские Пельмени]() 1:12:19
1:12:19
![Лева Грузовичок все серии]() 43:59
43:59
![Смешарики (большой сборник)]() 3:25:27
3:25:27
![Bakhtin - Целовала (Премьера клипа 2023)]() 3:16
3:16
![Винни-Пух. 1969 год.]() 41:23
41:23
![Jakone и Kiliana - Асфальт (Mood Video)]() 2:50
2:50
![Алдан (2025)]() 1:38:04
1:38:04
![Гордость и предубеждение | Pride & Prejudice (2005)]() 2:08:21
2:08:21
![Барбоскины 1-30]() 2:21:36
2:21:36
![Сборник На Кухне | Уральские Пельмени]() 1:30:27
1:30:27
![Домовёнок Кузя]() 1:29:32
1:29:32
![Клипы 90-х. Русский сборник хитов]() 1:29:27
1:29:27
![Лучшие в Аду (2022)]() 1:49:08
1:49:08
![Три Кота | Сборник домашних приключений | Мультфильмы для детей]() 45:14
45:14
![Зверополис 2 | Zootopia 2 (2025)]() 1:47:36
1:47:36
![28 лет спустя: Часть II. Храм костей | 28 Years Later: The Bone Temple (2026)]() 1:49:24
1:49:24
![Jazzdauren - Дарите женщинам цветы]() 3:09
3:09
![Буба - Все серии]() 3:06:34
3:06:34
![Рыцарь семи королевств. Все серии]() 3:28:06
3:28:06
![Три Кота 🐱 Сборник серий подряд | Смотреть онлайн развивающие мультики и игры для детей и малышей]() 3:16:51
3:16:51

 1:41:07
1:41:07Скачать Видео с Рутуба по ссылке
| 256x144 | ||
| 426x240 | ||
| 640x360 | ||
| 854x480 | ||
| 1280x720 | ||
| 1920x1080 |
 3:15
3:15
2026-05-30 11:43
 3:52
3:52
2026-05-09 18:11
 3:32
3:32
2026-05-21 11:40
 2:22
2:22
2026-05-15 10:20
 3:24
3:24
2026-05-16 13:20
 3:40
3:40
2026-05-15 10:04
 3:00
3:00
2026-05-26 11:26
 3:31
3:31
2026-05-21 20:27
 3:02
3:02
2026-05-26 10:55
 3:02
3:02
2026-06-04 09:55
 2:53
2:53
2026-05-21 14:27
 2:14
2:14
2026-05-24 15:19
 3:40
3:40
2026-05-16 13:14
 3:45
3:45
2026-04-29 14:24
 2:50
2:50
2026-06-04 09:50
 1:52
1:52
2026-05-15 13:19
 2:42
2:42
2026-06-14 12:22
 2:30
2:30
2026-06-02 13:00
 3:14
3:14
2026-05-02 00:31
 2:31
2:31
2026-05-16 13:10
0/0
 1:50:38
1:50:38
2026-05-20 08:38
 1:53:00
1:53:00
2026-03-27 14:10
 1:21:23
1:21:23
2026-05-28 20:15
 1:33:24
1:33:24
2026-05-27 11:57
 1:36:30
1:36:30
2026-05-06 14:10
 2:16:14
2:16:14
2026-04-20 11:54
 1:45:24
1:45:24
2026-06-05 12:15
 1:54:16
1:54:16
2026-05-28 20:15
 1:26:13
1:26:13
2026-04-29 20:33
 1:26:45
1:26:45
2026-03-27 13:34
 1:54:08
1:54:08
2026-03-21 11:57
 2:16:48
2:16:48
2026-03-12 23:31
 1:38:18
1:38:18
2026-05-12 16:55
 1:31:23
1:31:23
2026-05-27 11:57
 1:46:53
1:46:53
2026-05-26 12:53
 1:55:45
1:55:45
2026-06-10 09:28
 1:51:42
1:51:42
2026-05-26 13:06
 1:30:46
1:30:46
2026-03-28 23:09
 1:53:59
1:53:59
2026-04-22 11:21
 1:44:43
1:44:43
2026-04-09 22:40
0/0
2021-09-22 20:39
 13:00
13:00
2024-12-02 13:15
2021-09-22 22:23
2021-09-22 22:45
2021-09-23 00:15
 45:30
45:30
2025-12-11 18:53
 1:13
1:13
2024-11-29 14:40
2021-09-22 21:52
2021-09-22 22:54
 11:27
11:27
2025-10-10 18:25
2021-09-22 23:09
 0:00
0:00
2026-06-16 04:41
 3:27
3:27
2024-12-07 11:00
 7:04
7:04
2022-03-29 15:20
 11:11
11:11
2026-06-15 15:11
 7:08
7:08
2025-12-30 21:34
 7:42
7:42
2024-12-17 12:21
2021-09-22 22:07
2021-09-22 23:09
 1:28:31
1:28:31
2026-03-05 13:25
0/0
2025-04-18 22:01
2022-09-16 07:26
2025-01-24 05:04
 3:16
3:16
2023-10-13 14:26
2023-11-19 12:01
 2:50
2:50
2024-07-04 15:48
 1:38:04
1:38:04
2026-03-26 23:45
 2:08:21
2:08:21
2023-05-03 20:56
2024-12-16 20:15
2025-04-04 18:26
2025-03-15 20:49
2024-01-12 11:40
2022-10-20 11:01
 45:14
45:14
2020-04-22 20:10
 1:47:36
1:47:36
2025-12-25 17:49
 1:49:24
1:49:24
2026-02-19 14:08
 3:09
3:09
2024-05-30 14:13
2024-10-24 16:05
 3:28:06
3:28:06
2026-02-24 11:12
 3:16:51
3:16:51
2025-10-03 19:48
0/0

